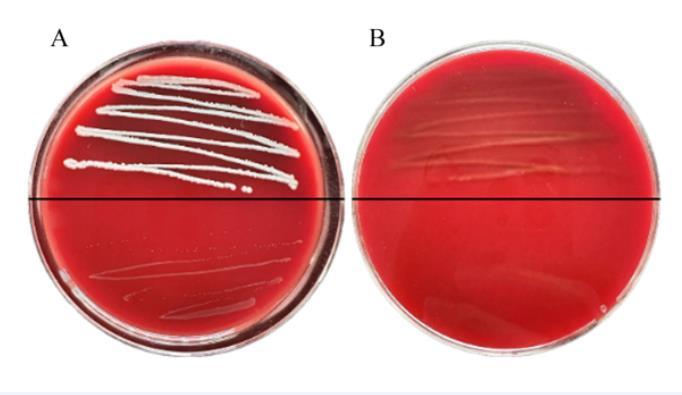

3.3.4 CLP51的耐受性
如表4所示,与正常培养条件37℃相比,CLP51经过60℃高温处理后其存活率为82.29%,即活菌数仍可以达到1.35×108 CFU/mL,具有较好的耐高温能力。
CLP51接种于pH=4的PBS 3 h后,存活率为105.81%,显著高于pH=2和pH=3时(P<0.05)。CLP51接种于pH=3的PBS 3 h后,存活率为99.30%,显著高于pH=2时(P<0.05)。
CLP51在0.1%、0.3%和0.5%胆盐中的存活率分别为102.77%、93.99%和93.30%,在0.1%胆盐中的存活率显著高于0.3%和0.5%胆盐中(P<0.05)。
CLP51在人工胃液、肠液和胃肠液中的存活率分别为41.63%、100.21%和46.19%,即活菌数分别为1.69×106、2.60×1010和5.31×106 CFU/mL,在人工肠液中的存活率显著高于人工胃液和胃肠液中(P<0.05)。
| 项目 Items | 存活率 Survival rate | P值 P-value |
|---|---|---|
| 50℃, 3 min | 102.02±1.32a | <0.001 |
| 60℃, 3 min | 82.29±0.60b | |
| pH=2 | 0c | <0.001 |
| pH=3 | 99.30±0.28b | |
| pH=4 | 105.81±3.26a | |
| 0.1%胆盐 0.1% bile salt | 102.77±5.32a | 0.019 |
| 0.3%胆盐 0.3% bile salt | 93.99±0.52b | |
| 0.5%胆盐 0.5% bile salt | 93.30±1.34b | |
| 人工胃液 Artificial gastric juice | 41.63±1.53b | <0.001 |
| 人工肠液 Artificial intestinal juice | 100.21±1.29a | |
| 人工胃肠液 Artificial gastrointestinal fluid | 46.19±7.18b |
3.3.5 CLP51的表面疏水率和自凝聚率
如表5所示,CLP51在二甲苯:氯仿=1:1的混合液中表面疏水率显著高于在二甲苯和氯仿中(P<0.05),在二甲苯、氯仿中的表面疏水率无显著差异(P>0.05),均属于高度疏水。
CLP51在16和24 h的自凝聚率显著高于在8 h(P<0.05),在8、16和24 h的自凝聚率分别为81.57%、94.63%和95.53%,说明CLP51具有良好的自凝聚性。
| 项目 Item | 表面疏水率 Surface hydrophobicity rate | 自凝聚率 Self-coagulation rate | ||||||
|---|---|---|---|---|---|---|---|---|
| 二甲苯 Xylene | 氯仿 Chloroform |
二甲苯:氯仿=1:1 Xylene:chloroform=1:1 |
P值 P-value | 8 h | 16 h | 24 h | P值 P-value | |
| 犬源植物乳杆菌51 CLP51 | 65.06±1.98b | 62.08±3.77b | 79.84±1.39a | <0.001 | 81.57±3.94b | 94.63±1.15a | 95.53±0.35a | 0.001 |
3.3.6 CLP51的抑菌活性
如图4所示,CLP51的菌悬液和无细胞上清液能够有效抑制大肠杆菌、金黄色葡萄球菌、沙门氏菌、铜绿假单胞菌和单核细胞增生李斯特菌的生长增殖,而CLP51的菌体沉淀无抑菌作用。

图4 CLP51的抑菌活性
A:大肠杆菌;B:金黄色葡萄球菌;C:沙门氏菌;D:铜绿假单胞菌;E:单核细胞增生李斯特菌;a:菌悬液;b:无细胞上清液;c:菌体沉淀;d:MRS肉汤。
如表6所示,CLP51的无细胞上清液的抑菌效果为:单核细胞增生李斯特菌 > 大肠杆菌 > 铜绿假单胞菌 > 沙门氏菌 > 金黄色葡萄球菌,CLP51的菌悬液的抑菌效果为:单核细胞增生李斯特菌 > 铜绿假单胞菌 > 大肠杆菌 > 沙门氏菌 > 金黄色葡萄球菌。
| 项目 Items | 抑菌圈直径 Diameter of inhibition zone | |
|---|---|---|
|
无细胞上清液 Cell-free supernatant |
菌悬液 Bacterial suspension |
|
| 大肠杆菌 Escherichia coli | 19.85±0.79b | 20.79±1.78bc |
| 金黄色葡萄球菌 Staphylococcus aureus | 14.88±0.72d | 16.03±0.67d |
| 沙门氏菌 Salmonella | 17.48±0.30c | 17.78±0.21cd |
| 铜绿假单胞菌 Pseudomonas aeruginosa | 19.74±1.15b | 21.78±2.72ab |
| 单核细胞增生李斯特菌 Listeria monocytogenes | 23.14±0.76a | 24.91±2.19a |
| P值 P-value | 0.001 | <0.001 |
3.3.7 CLP51的抗生素敏感性
药敏片直径为6 mm,设抑菌圈(透明圈)直径大于7 mm的为具有抑菌性,小于等于7 mm视为无抑菌性。如表7所示,CLP51对克林霉素敏感性强,对氯霉素、亚胺培南、头孢唑林和氟苯尼考等中度敏感,对阿奇霉素、林可霉素、庆大霉素等低度敏感,对万古霉素、多黏菌素B等不敏感。
| 抗生素 Antibiotics | 浓度 Concentrations/ (μg/片) | 结果 Results | 抗生素 Antibiotics | 浓度 Concentrations/ (μg/片) | 结果 Results |
|---|---|---|---|---|---|
| 青霉素 PEN | 10 | — | 阿米卡星 AMK | 30 | + |
| 苯唑西林 OX | 1 | — | 庆大霉素 GEN | 10 | + |
| 氨苄西林 AMP | 10 | — | 卡那霉素 KAN | 30 | — |
| 哌拉西林 PIP | 100 | — | 链霉素 S | 10 | — |
| 头孢氨苄 CN | 30 | — | 四环素 TET | 30 | — |
| 头孢唑林 CZ | 30 | ++ | 米诺环素 MI | 30 | — |
| 头孢呋辛 CXM | 30 | — | 红霉素 E | 15 | ++ |
| 头孢他啶 CAZ | 30 | — | 阿奇霉素 AZI | 15 | + |
| 头孢曲松 CRT | 30 | + | 诺氟沙星 NOR | 10 | — |
| 头孢哌酮 CPZ | 75 | + | 环丙沙星 CIP | 5 | — |
| 林可霉素 MY | 2 | + | 克林霉素 CC | 2 | +++ |
| 万古霉素 VAN | 30 | — | 左氧氟沙星 LEV | 5 | + |
| 多黏菌素B PB | 300 | — | 亚胺培南 IPM | 10 | ++ |
| 复方新诺明 SXT | 25 | ++ | 强力霉素 DO | 30 | + |
| 氯霉素 C | 30 | ++ | 氟苯尼考 FFC | 30 | ++ |
透明圈直径(mm):+++代表23~30 mm;++代表15~22 mm;+代表7~14 mm;—代表没有抑菌圈。
3.4 CLP51的安全性评价
3.4.1 溶血试验
如图5-A所示,阳性对照的金黄色葡萄球菌表现出β-溶血;如图5-B所示,CLP51表现为γ-溶血(无溶血环),可初步判断CLP51安全,无溶血性。
图5 金黄色葡萄球菌和CLP51的溶血试验
3.4.2 小鼠安全性试验
3.4.2.1 CLP51对小鼠生长性能的影响
试验期间未有小鼠死亡,临床观察所有小鼠精神状况良好,摄食、饮水、粪便形态均正常。试验结束后剖检观察其内脏色泽、质地、体积等均未见病变,说明CLP51对小鼠临床应用无毒副作用。如图6所示,各组之间小鼠体重、平均日增重和平均日采食量均无显著差异(P>0.05)。

图6 CLP51对小鼠生长性能的影响
3.4.2.2 CLP51对小鼠器官指数的影响
如表8所示,各组之间小鼠各器官指数均无显著差异(P>0.05)。
| 项目 Items | 组别 Groups | P值 P-value | |||
|---|---|---|---|---|---|
| CON | L | M | H | ||
| 心脏 Heart | 0.59±0.08 | 0.59±0.11 | 0.61±0.07 | 0.63±0.15 | 0.889 |
| 肝脏 Liver | 4.84±0.42 | 4.88±0.80 | 4.32±0.73 | 4.55±0.58 | 0.216 |
| 脾脏 Spleen | 0.52±0.19 | 0.52±0.16 | 0.47±0.13 | 0.37±0.47 | 0.063 |
| 肾脏 Kidney | 1.39±0.06 | 1.25±0.16 | 1.30±0.16 | 1.38±0.23 | 0.192 |
| 胸腺 Thymus | 0.18±0.06 | 0.21±0.13 | 0.19±0.06 | 0.25±0.10 | 0.274 |
相关新闻推荐
3、24株II组肉毒梭菌菌株最低和最高生长温度下的生长速率测定(二)
